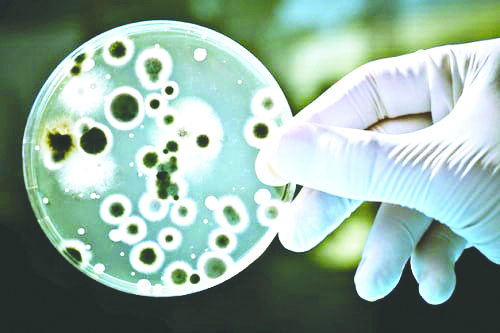

Ben yedim bi'şi olmadı.. Ben içtim bi'şi olmadı!..
Bu kafayla giderseniz, bir gün bi'şi ve meselâ Bruselloz virüsü kapar, "Malta Humması" olursunuz.
Bruselloz virüsü, Malta Humması, Akdeniz Humması, Mal Hastalığı olarak da bilinen hayvanlardan insanlara bulaşan bir virüs çeşididir. Bruselloz virüsü beraberinde çeşitli hastalıkları da meydana getirebilir.
Bruselloz, hafif belirtilerden ağır klinik tablolara kadar değişebilen özellikte, belirti ve bulgularının spesifik olmaması sebebiyle birçok hastalığı taklit edebilen sistemik bir hastalık..
Bizim gibi "Bana, bize bi'şi olmaz!" zihniyetinin yaygın olduğu ülkelerde yaygın tehlikedir.
Dünya sağlık örgütü verilerine göre dünyada en sık rastlanan bakteriyel hastalıktır ve her yıl yaklaşık 500.000 yeni hadise bildirilmektedir.
Tarihte ilk defa 1861'de Marston tarafından Malta adasındaki İngiliz askerlerinde fark edildi ve bu adı aldı.
Yıllar içerisinde farklı hayvan türlerinden çeşitli Brusella türleri tesbit edilmiştir.
Hastalık bütün dünyada görülmekle birlikte özellikle Akdeniz ülkeleri (Fransa, Portekiz, İspanya, Malta, Yunanistan ve Türkiye), Arabistan, Hindistan, Meksika, Brezilya, Orta ve Güney Amerika da yaygın..
Bizde endemik olarak görülen hastalık özellikle İç, Doğu ve Güneydoğu Anadolu illerinde yoğunlaşmaktadır.
Et, süt, peynir..
Brusella virüsleri, sığır, koyun, keçi, hayvanların etleri ve sütleri ile bulaşabilmektedir.
Kaynatılmadan hazırlanan süt ve süt ürünlerinin tüketilmesi en önemli etken.. Yapılan çalışmalarda; Brusella virüsleri, taze peynirde 3 ay, soğuk şartlarda saklanılması durumunda 6 aya kadar, tuzsuz kremada 142 gün, %10 tuzlu peynirde 45 gün, %17 tuzlu peynirde 1 ay, tereyağında 4 ay, dondurmada 1 ay canlı kalabilmekte ve hastalığa yol açabilmektedir.
Fermantasyon ile hazırlanan kaşar peynir, yoğurt ve ekşitilmiş sütte enfeksiyonun bulaşma riski daha azdır.
Et ve et ürünleri ile bulaşma riski, iyi pişmiş tüketilmesinde kas içerisindeki bakteri sayısı az olacağından düşüktür.
"Az pişmiş" merakı
Ancak karaciğer, dalak, böbrek, gibi sakatatta bakteri konsantrasyonu yüksektir.
Et ürünlerinin hiçbiri çiğ tüketilmemelidir.
Hele hele yukarıdaki fotoğrafta olduğu gibi "az pişmiş" merakınız varsa, bir gün başınıza iş açabilir.
Hayvan çiftliklerinde çalışanlar, çiftçiler, veterinerler, suni dölleme işi ile uğraşanlar hasta hayvan ile temas ihtimali açısından yüksek riskli gruplardır.
Hayvancılık yapan aile fertleri, hasta hayvan yavrularına bakan çocuklar, hayvansal gıda üretiminde çalışan kasaplar, süt ve süt ürünleri hazırlama işinde çalışanlar yün ve deri ile işlerinde çalışanlar, doğrudan temasla deride sıyrık, kesik yüzünden virüs kapabilir.
Akut ise 38.5 kronik halde ise nadiren ateş yapıyor
Brusellozun ilk belirtileri bitkinlik, yemek yememe isteksizliği, aşırı ateş, gece terlemeleridir. Ardından eklem ve kas ağrıları ile beraber agresiflik baş gösterir.
Bakterinin vücuda alınmasından 2-4 hafta içerisinde hastalık belirtileri başlar.
Sıklıkla yüksek ateş, terleme, yorgunluk, iştahsızlık, baş ağrısı, sırt ağrısı, eklem ağrısı olabilir. Kilo kaybı, bulantı, kusma, kas ağrısı, ishal/kabızlık görülebilir. Depresyon izlenebilir.
Akut formda; Çoğunlukla yüksek ateş 38.5 derecenin üzerindedir.
Halsizlik, iştahsızlık, baş ağrısı, sırt ağrısı, kilo kaybı, miyalji, artralji vardır. Artrit, karaciğer ve dalakta büyüme, karaciğer fonsiyon testlerinde yükselme izlenebilir.
Kronik formda; Yaşlılarda sık görülür. Depresyon gibi psikyatrik durumlardan, halsizlik, çabuk yorulma, güç kaybı, terleme, kilo kaybı görülebilir. Ateş ise nadirdir.
Geçici işitme kaybı, vertigo da görülebilmektedir.
Hastalık belirti ve bulgularından şüphelenilen durumlarda Enfeksiyon Hastalıkları ve Klinik Mikrobiyoloji polikliniğine başvurulmalıdır.